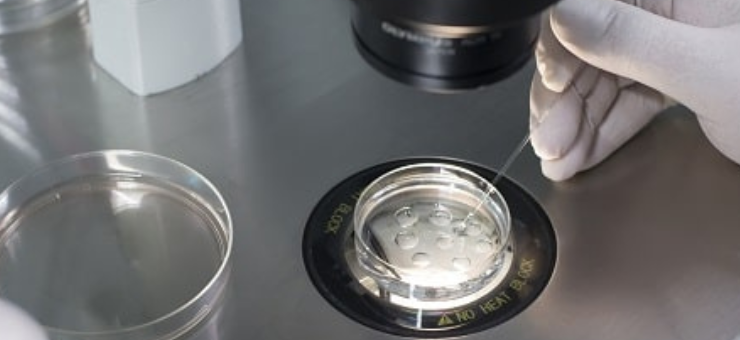
Add Ons To IVF Success

GIVE BIRTH TO YOUR DREAM
About Us
DREAMZ IVF is recognized as the Best IVF Clinic in Delhi, offering advanced and result-oriented infertility treatments. The clinic was conceptualized by Dr. Shikha Jain with the aim of providing scientifically proven fertility solutions to childless couples and helping them achieve their dream of parenthood. She is committed to providing ethical and affordable fertility care to every patient.
At DREAMZ IVF, each couple is carefully evaluated and provided with an individualized treatment plan based on their specific needs. By adopting the latest medical protocols and advanced reproductive technologies, the clinic strives to deliver the highest IVF success rates while helping families grow.
Over


Services Offered
We are well equipped
Pre Treatment Evaluation And Counseling
Pelvic Ultrasound And Follicular Monitoring
Hormonal Assays
Tubal Patency Tests
Ovulation Induction
Diagnostic Laparoscopy And Hysteroscopy
Endometrial Receptivity Array (ERA)
Pre- treatment Evaluation & Counselling
Advanced Semen Analysis
Hormonal assays
Sperm Function Test
DNA Fragmentation Test
Semen Culture
Evaluation of Unexplained Infertility
Ovarian Drilling
Adhesiolysis
Ovarian Cystectomy
Fimbrioplasty
Myomectomy
Polypectomy
Septal Resection/ Metroplasty
Hysteroscopic Synechiolysis
Cornual Catheterisation
Intrauterine Insemination (IUI)
In Vitro Fertilization (IVF)
Intracytoplasmic Sperm Injection (ICSI), P-ICSI & IMSI
Blastocyst Transfer
Laser Assisted Hatching
Freezing of Sperms/Oocytes/ Embryos
Surgical Sperm Retrieval: PESA/TESA/TESE/ MicroTESE
Third Party Reproduction: Donor Sperm/ Egg/ Surrogacy
Pre Implantation Genetic Testing
Meet Our Doctors
Specialist

DR. AJAY JAIN

Dr. Shikha Jain
| GOLD MEDALIST | CONSULTANT REPRODUCTIVE MEDICINE, Gynae Endoscopy & IVF |
Our Skills
Our fully equipped reproductive centre offers the latest fertility technology and comfort. We can help people with infertility and reproductive difficulties.
Over
People Recommend Us
Why Choose us
We provide individualized care and attention for every couple during their journey to parenthood. We offer comprehensive testing to determine the causes of male and female infertility. Our area of expertise include IUI, IVF, ICSI, Egg Donation & Surrogacy.